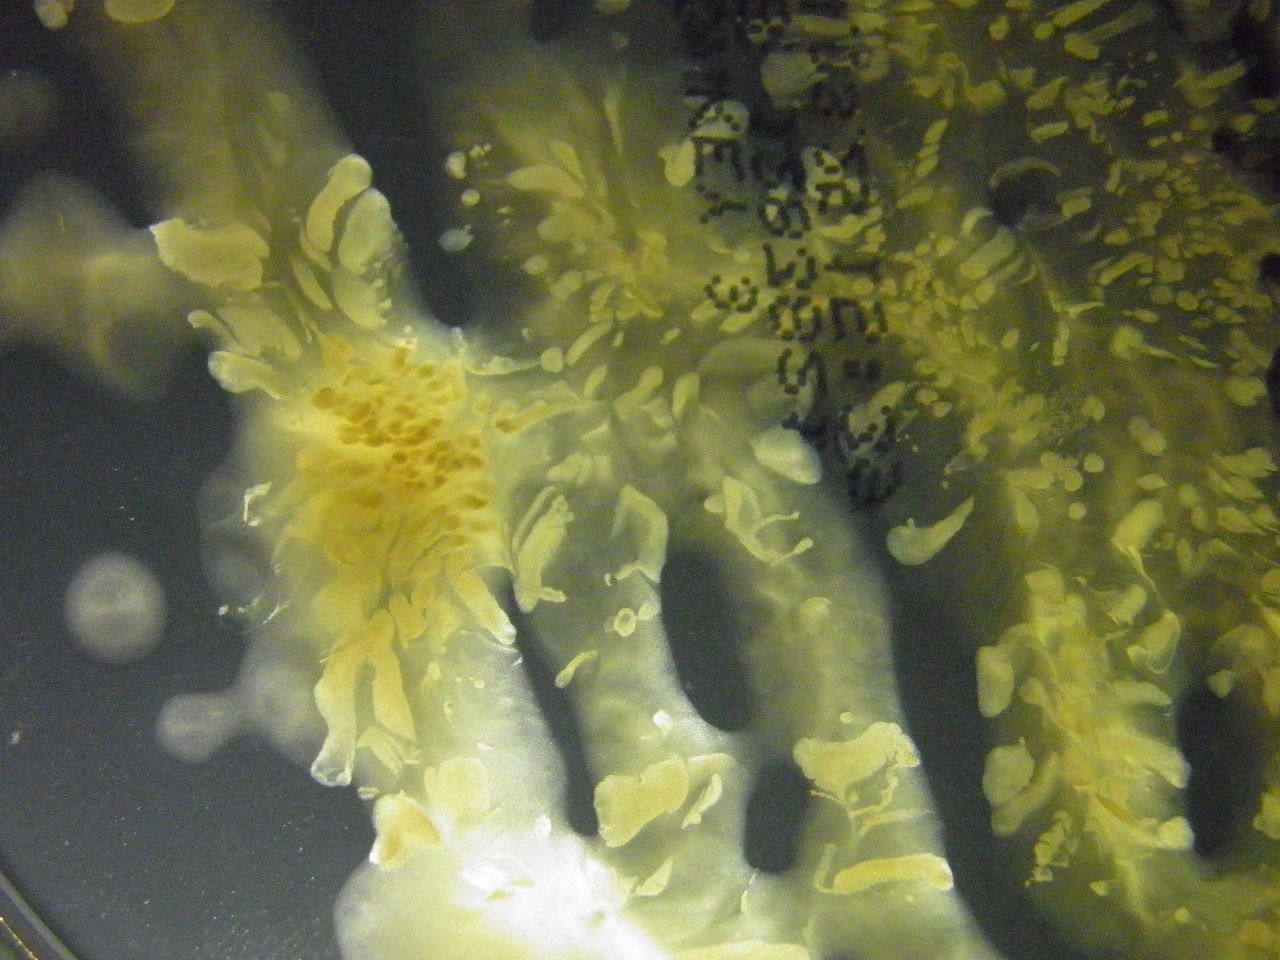

Nuevas perspectivas en la ecología bacteriana pulmonar de la fibrosis quística
Encuentran por primera vez bacterias depredadoras en el microbioma de los enfermos de fibrosis quística pulmonar. Entre los autores de este hallazgo se encuentran investigadores de la Universidad Politécnica de Madrid.
16.10.2017
Los resultados obtenidos por un equipo de investigadores del Hospital Universitario Ramón y Cajal, el Instituto Ramón y Cajal de Investigación Sanitaria (IRYCIS) y la ETS de Ingeniería Agronómica, Alimentaria y de Biosistemas (ETSIAAB) de la Universidad Politécnica de Madrid (UPM) permiten diseñar un modelo computacional para erradicar los patógenos de la fibrosis quística pulmonar mediante la inoculación de bacterias depredadoras. El trabajo ha sido publicado en la revista mBio de la Sociedad Americana de Microbiología.
Las nuevas herramientas de secuenciación genética -next-generation sequencing (NGS), como se las conoce en inglés- están permitiendo constatar una enorme complejidad en el microbioma pulmonar e identificar una gran cantidad de bacterias de las que se desconocía su presencia en los enfermos de fibrosis quística pulmonar.
Foto: Bacterias encontradas en enfermos de fibrosis quística pulmonar. Fotografía: Rosa del Campo. Servicio de Microbiología del Instituto Ramón y Cajal de Investigación Sanitaria (IRYCIS).
En un estudio en el que ha participado el grupo de Sistemas Complejos de la UPM, se han utilizado estas herramientas NGS para monitorizar las fluctuaciones del ecosistema del microbioma de 15 pacientes con fibrosis quística pulmonar durante un período de un año y se ha descrito por primera vez la presencia de dos tipos de bacterias depredadoras en el microbioma pulmonar de este tipo de enfermos: Bdellovibrio y Vampirovibrio. La aparición de estas bacterias depredadoras ha inspirado el trabajo computacional de un modelo basado en agentes donde se reproducen los comportamientos de depredador y presa. Los modelos introducen inicialmente 5000 agentes con cinco especies diferentes: dos especies con roles de depredadores y tres especies con el de presa. Variando las cantidades iniciales de depredadores se llega a las soluciones clásicas de los modelos de tipo Lotka-Volterra: extinción total de todas las especies o convivencia de una especie depredadora y otra especie presa.
Como señala Javier Galeano, uno de los investigadores implicados en el estudio, “los resultados de estos modelos nos permiten realizar la hipótesis de que inoculando este tipo de depredadores, ya existentes en el microbioma pulmonar, se podría contribuir a erradicar los patógenos de la fibrosis quística pulmonar en los estadios iniciales de dicha colonización”.
de Dios Caballero J, Vida R, Cobo M, Máiz L, Suárez L, Galeano J, Baquero F, Cantón R, del Campo R, GEIFQ Study Group. 2017. Individual Patterns of Complexity in Cystic Fibrosis Lung Microbiota, Including Predator Bacteria, over a 1-Year Period. mBio vol. 8, nº. 5. September 2017.


